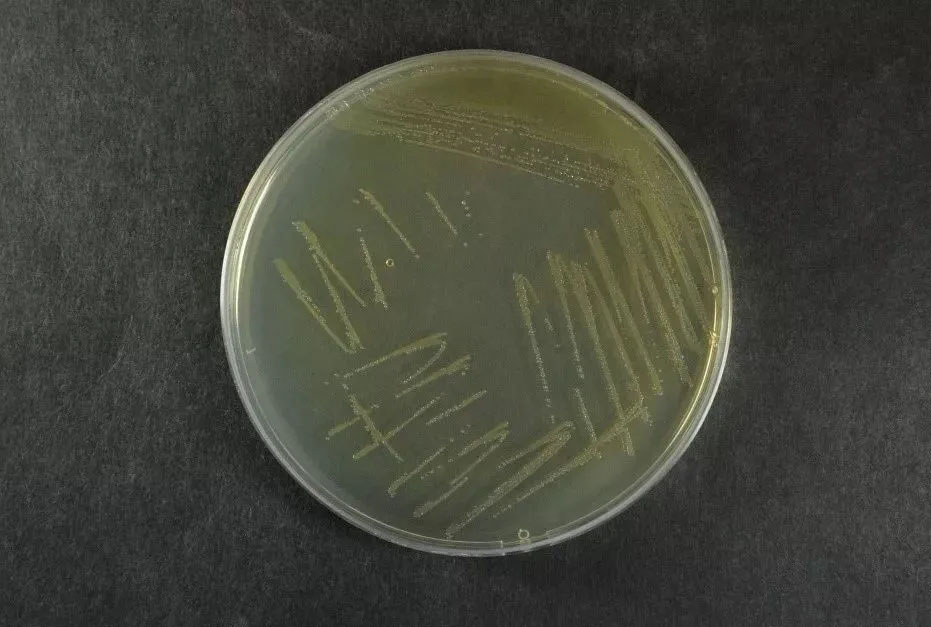

海博微信公众号
海博微信公众号
 海博天猫旗舰店
海博天猫旗舰店


 海博微信公众号
海博微信公众号
 海博天猫旗舰店
海博天猫旗舰店




形态学

CICC 10474 CC平板菌落形态

CICC 10474 mCPC平板菌落形态
CICC 10474 3% NaCl TSA平板菌落形态

CICC 10474菌体形态
关键生化特性
|
3% TSI |
- |
|
动力 |
+ |
|
氧化酶 |
+ |
|
赖氨酸 |
+ |
|
V-P |
- |
|
蔗糖 |
- |
|
葡萄糖 |
+ |
|
D-纤维二糖 |
- |
|
乳糖 |
- |
|
ONPG |
+ |
|
嗜盐性实验 |
|
|
NaCl含量0% |
+ |
|
NaCl含量3% |
+ |
|
NaCl含量6% |
+ |
|
NaCl含量8% |
- |
|
NaCl含量10% |
- |


嗜盐性试验

3%氯化钠三糖铁琼脂穿刺试验
上一篇:突柄微菌属种的描述之水生突柄微菌
下一篇:生金菌属种的描述之覆盖生金菌
| 相关文章: |



